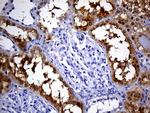
PHYHD1 Antibody in Immunohistochemistry (Paraffin) (IHC (P))
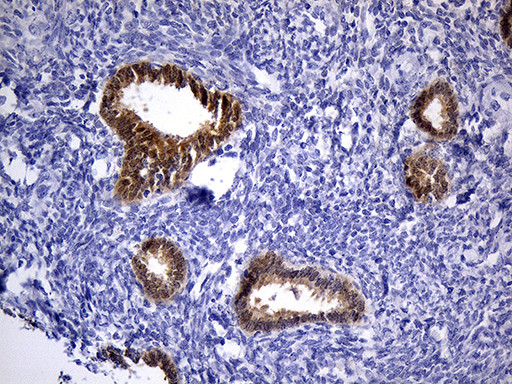
PHYHD1 Antibody in Immunohistochemistry (Paraffin) (IHC (P))

Search
OriGene
PHYHD1 Monoclonal Antibody (OTI1A6), TrueMAB™
{{$productOrderCtrl.translations['antibody.pdp.commerceCard.promotion.promotions']}}
{{$productOrderCtrl.translations['antibody.pdp.commerceCard.promotion.viewpromo']}}
{{$productOrderCtrl.translations['antibody.pdp.commerceCard.promotion.promocode']}}: {{promo.promoCode}} {{promo.promoTitle}} {{promo.promoDescription}}. {{$productOrderCtrl.translations['antibody.pdp.commerceCard.promotion.learnmore']}}
图: 1 / 5
PHYHD1 Antibody (TA811367) in IHC (P)

产品信息
TA811367
种属反应
宿主/亚型
分类
类型
克隆号
抗原
偶联物
形式
浓度
纯化类型
保存液
内含物
保存条件
运输条件
靶标信息
PHYHD1 (phytanoyl-CoA dioxygenase domain containing 1) is a 291 amino acid protein belonging to the PHYH family and the PHYHD1 subfamily. Encoded by a gene that maps to human chromosome 9q34.11, PHYHD1 exists as three alternatively spliced isoforms and likely functions as an alpha-ketoglutatare-dependent dioxygenase. PHYHD1 participates in metal ion binding and oxidoreductase activity, thereby acting on single donors with incorporation of two atoms of oxygen. Related to PHYH (phytanoyl-CoA 2-hydroxylase), an Fe(II) and 2-oxoglutarate (2OG)-dependent oxygenase that catalyzes the initial alpha-oxidation step in the degradation of phytenic acid in peroxisomes, PHYHD1 similarly exhibits additional homologues in a wide range of metazoans and bacteria. PHYHD1 also may play a role in DNA methylation in early postnatal liver development and mammalian differentiation.
仅用于科研。不用于诊断过程。未经明确授权不得转售。
篇参考文献 (0)
生物信息学
蛋白别名: Phytanoyl-CoA dioxygenase domain-containing protein 1; Protein PHYHD1
基因别名: PHYHD1
UniProt ID: (Human) Q5SRE7
Entrez Gene ID: (Human) 254295